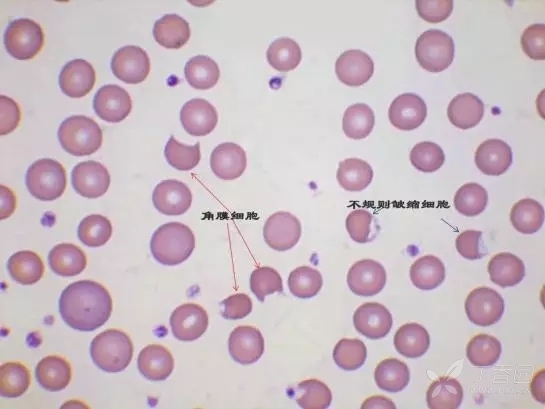
上传张碎裂红细胞的图片加深各位战友的认识,图片来源于网络
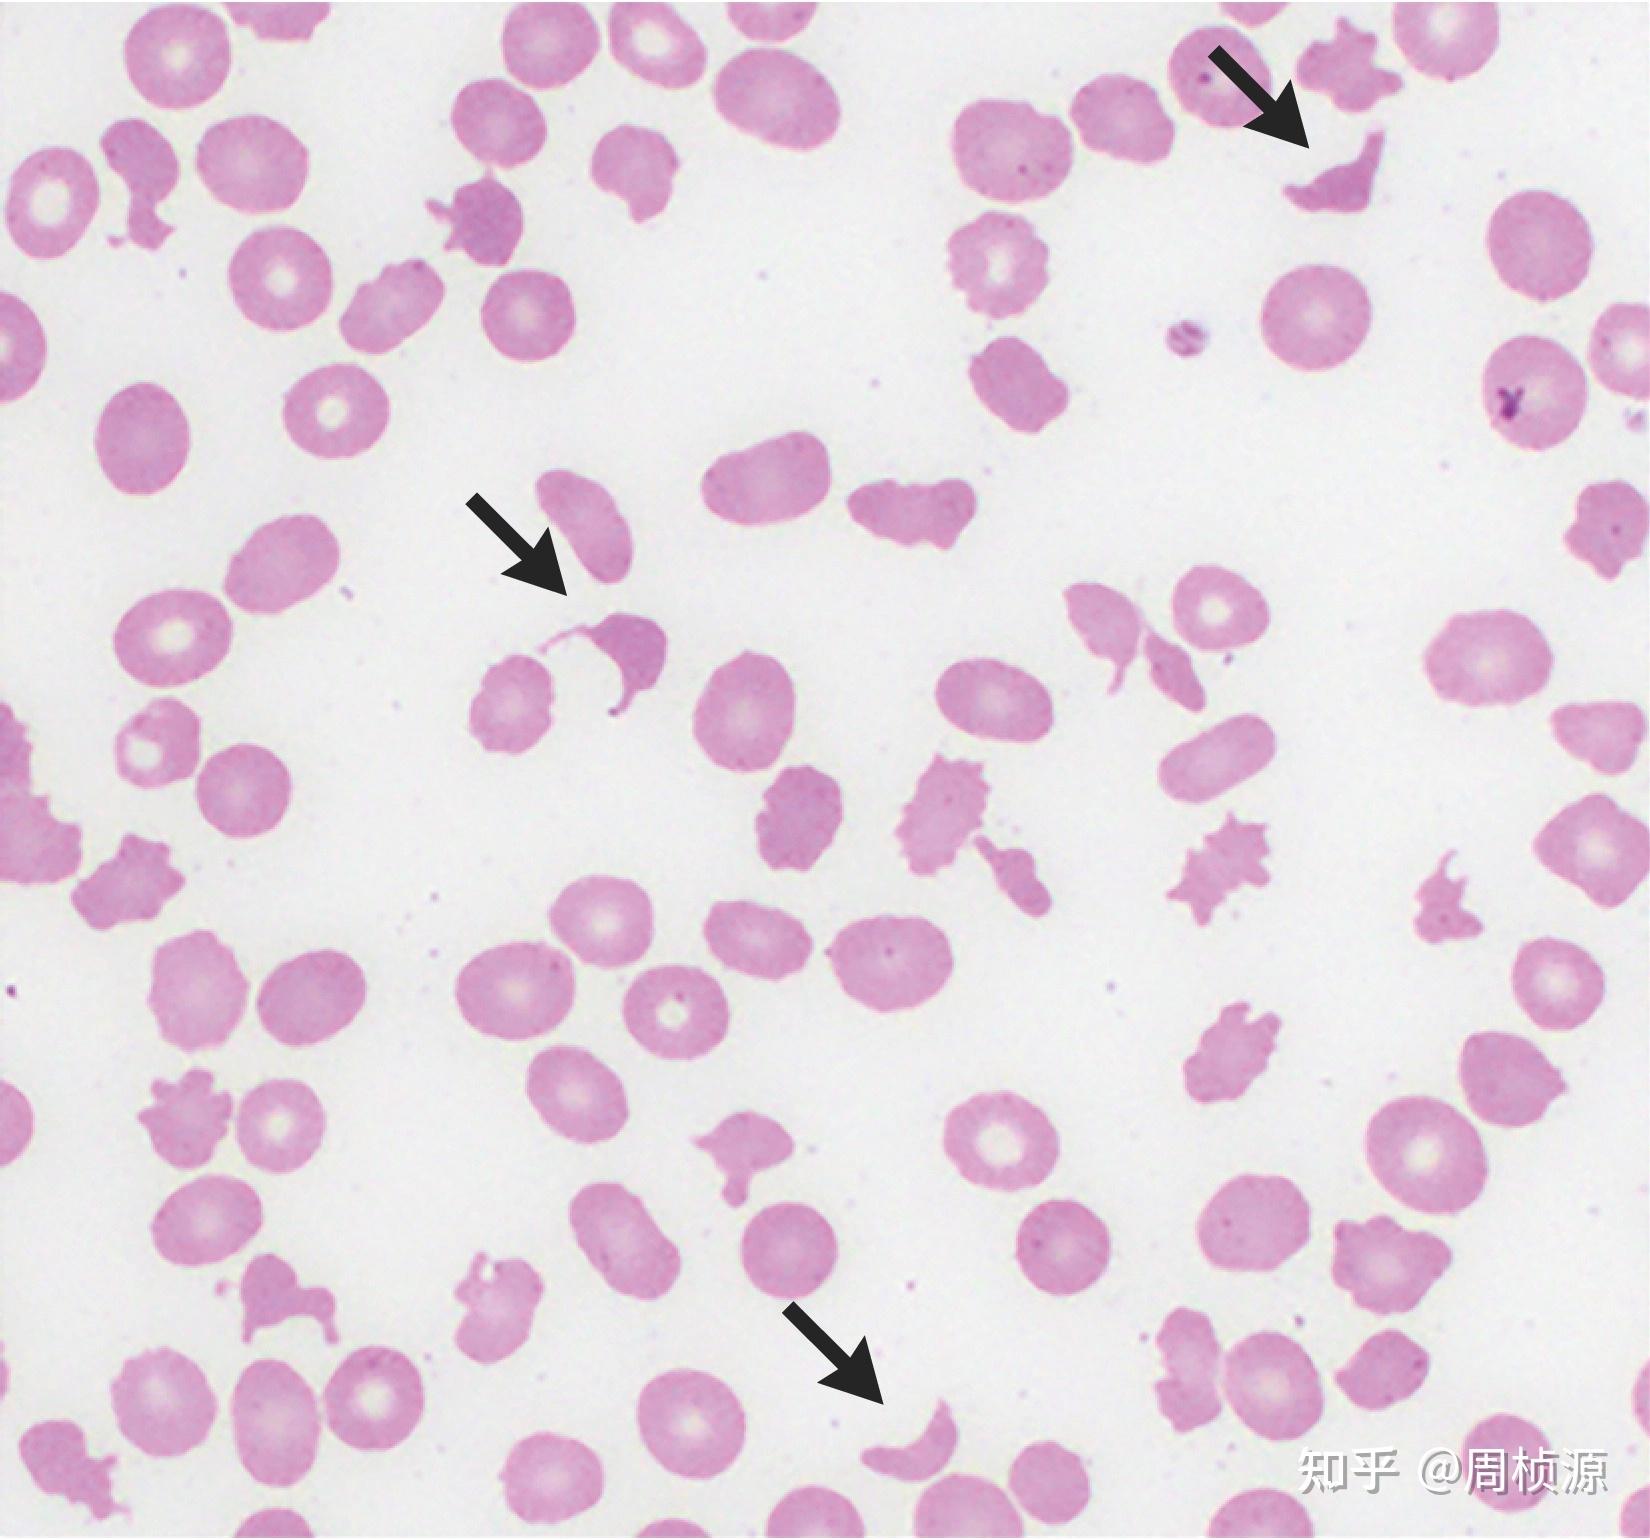
外周血涂片示破碎红细胞,红细胞大小不等,血小板少,伴大血小板,白细胞

破碎红细胞

一个裂片红细胞与ttp的案例及思考
图片尺寸411x310
破坏血红细胞上白色背景 3d 图
图片尺寸700x394
(图) 畸形和碎片红细胞
图片尺寸1130x905
外周血涂片可见棘形红细胞,头盔形红细胞,破碎红细胞占7%.如图1
图片尺寸650x488
这时我相信这些红细胞碎片就是导致血小板假性升高的原因,但这些
图片尺寸551x464
破坏红细胞
图片尺寸1200x800
上传张碎裂红细胞的图片加深各位战友的认识,图片来源于网络
图片尺寸545x409
红细胞缺少应该怎样补充有效
图片尺寸500x313
那些年,曾经被混淆过的红细胞_手机搜狐网
图片尺寸634x486
红细胞|血小板|外周血|血浆|溶血_网易订阅
图片尺寸660x655
外周血涂片示破碎红细胞,红细胞大小不等,血小板少,伴大血小板,白细胞
图片尺寸1650x1540
红色的血细胞叫红细胞破裂进入中部照片
图片尺寸300x300
图 5 遗传性椭圆红细胞增多症 ② 破碎红细胞(裂红细胞,头盔状细胞,红
图片尺寸358x238
隐藏的心脏病:11个你不可不知的皮肤病变线索
图片尺寸560x320
红细胞从破裂的血管中流出
图片尺寸500x370
红细胞从破裂的血管中涌出
图片尺寸500x341
从破裂血管中渗出的红细胞氧化型维生素c(脱氢抗坏血酸)晶体/拍摄者
图片尺寸333x450
图片浏览
图片尺寸207x207
都是红细胞惹的祸
图片尺寸900x909
红细胞图片
图片尺寸1280x853